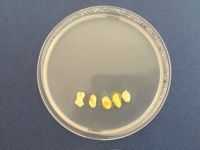

October 25th
Learned about slime molds. Extracted slim molds on the agar medium in two plastic culture dishes, one fed by oats in a cube shape and another in circle shape. And I intended to find out if they can grow in the way I expected.
November 1st
Checked the growing of the slime molds after one week. Out of expectation, they grew in different directions and didn't form a specific shape. On the cube dish, slime molds grew around 2 of the oats; on the circle dish, they grew around 4 of the oats with different amounts. However, something interesting is that they both grew on the walls of the dishes and seemed like trees.
November 29th-IDEA
Growing slime molds on a face-like pattern. According to the situations they grow, it can be imagined as different hair styles or beard and so on. Also, it can be imagined people will be in different emotions (happiness, sadness ,confusing...)according to the all kinds of hair styles.
December 13th
Extracted the slime molds in three different dishes on the agar medium. One is the tube with oats randomly to imagine the faces or other figures on the wall of the tube. The second one is the dish with a cutting face and put the oats on the head, also slime molds were put on three of them. The last one is the dish with 5 oats in a line without being restricted by the face.
December 14th
Observed the change of the growing at 12pm and 21:30pm.
December 14th - December 20th Observation GIF
Summary: 1.Slime molds didn't grow out of my expectation in a dispersed way. They grew towards different directions in different time (from right side to left, and back to right ). The trails of growing became white from yellow, also they grow so fast and I didn't document all of the changes. Also they didn't form the shape as my expectation, so I would try to change the times of observation and documents. 2.There are some other bacteria inside breaking the pure of slime molds. Also I am not sure if the bacteria influenced the diffusion of slime molds 3.I tried use the tube with agar full of inside to grow slime molds. Unfortunately, slime molds were only alive around one piece of oat, and becoming sick 7days later. However, there is no other bacteria growing up! So I intend to use tube with smooth surface(The failed one is the tube with Agar rotated inside which is not smooth.) of Agar and grow slime molds to test what kind of shape will be formed in the tube space.
December 20th